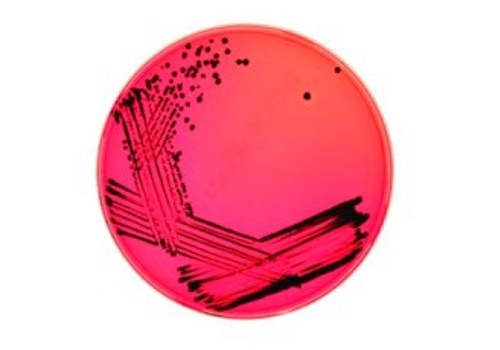

Rare Salmonella serotype deposited into the NCTC
The subject of a complex history of taxonomic re-interpretation and a dynamic nomenclature, the genus Salmonella is currently comprised of only two validly described species; Salmonella enterica and Salmonella bongori. Salmonella enterica is comprised of 6 sub-species, of which the most dominant in human infection is Salmonella enterica subsp. enterica (also known as Salmonella enterica subsp. I)1.
Like all sub-species of Salmonella enterica, strains of the sub-species enterica can be distinguished and typed by determination of the structure of cell surface antigens; the O antigen determined by cell wall composition and the H antigen determined by flagellar proteins. Known as the White-Kauffmann-Le Minor scheme, there are approximately 1600 serological variants (“serovars” or “serotypes”) for Salmonella enterica subsp. enterica alone2,3. The WHO Collaborating Centre for Reference and Research on Salmonella based at the Institut Pasteur in Paris is responsible for the maintenance and publication of this scheme, and for the validation and naming of new serovars. The centre serves as the centralised authoritative source of information on the names and structural formulae of Salmonella serovars, enabling clarity when using and interpreting this historical and vast Salmonella serovar typing scheme2,3.
A rare serotype is Salmonella enterica subsp. enterica serotype Adjame, or Salmonella Adjame. Until 2017, there had only be 16 reported cases of Salmonella Adjame in the UK (between 1993-2016), and the serotype had never been isolated from livestock or animal feed in Great Britain. Earlier this year, scientists from Public Health England’s Gastrointestinal Bacteria Reference Unit and collaborators described the first known outbreak of Salmonella Adjame since the serovar’s original isolation in 1966 in west Africa, which occurred in 2017 in London, UK. 31 Salmonella isolates were typed, including the 2017 outbreak strains, historic and reference strains. Genomic analysis of these strains revealed three genetically distinct clusters, with a representative outbreak strain from each cluster being deposited into the NCTC as NCTC 14246, NCTC 14247 and NCTC 142484.
The Adjame serovar was previously not represented in the National Collection of Type Cultures. The accession of these three strains provides access to uncommon pathogens to the research, diagnostic and public health communities, and may help provide context and clarity for future such atypical outbreaks of Salmonella or in areas of the world where Salmonella Adjame is more common (the authors of Chattaway MA et al. cite the lack of available sequenced isolates of Salmonella Adjame as challenging when initially identifying the outbreak strains/serovar).
FASTQ sequences for each strain were deposited in the NCBI Short Read Archive under the BioProject PRJNA248792. The SRA accession numbers for each strain are listed below and can be found in the NCTC online catalogue.
be found in the NCTC online catalogue.
NCTC No. |
Chattaway MA et al. cluster |
NCBI SRA accession |
---|---|---|
Cluster 1 |
||
Cluster 2 |
||
Cluster 3 |
Depositing strains into the National Collection of Type Cultures is a free service and is encouraged; the NCTC actively accessions bacterial strains which are uncommon pathogens, are diagnostic escape mutants or that have unusual clinical presentation or aberrant phenotypes. More information on the depositing process can be found on the 'How to deposit strains with NCTC' page.
References
- Tindall, B. J., et al. (2005). "Nomenclature and taxonomy of the genus Salmonella." Int J Syst Evol Microbiol 55(Pt 1): 521-524.PMID:15653930
- https://research.pasteur.fr/en/whocc/salmonella/
- Issenhuth-Jeanjean, S., et al. (2014). "Supplement 2008-2010 (no. 48) to the White-Kauffmann-Le Minor scheme." Res Microbiol 165(7): 526-530. PMID: 25049166
- Chattaway, M. A., et al. (2019). "Genomic approaches used to investigate an atypical outbreak of Salmonella Adjame." Microb Genom 5(1). PMID:30648934
Copy prepared By Jake Turnbull (twitter: @HotchPotchJake)